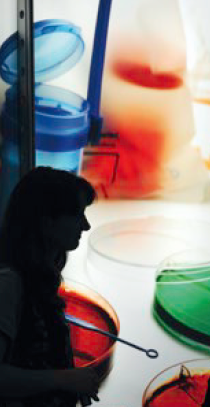

Biotechnica 2013: Zentrum der Biotechnologie in Europa

Mit neuen Themen und innovativen Marktplätzen wird die Biotechnica 2013 in Hannover wieder für drei Tage lang das Zentrum der Biotechnologie- Branche in Europa sein. Bereits zum 20. Mal bringt sie vom 8. bis zum 10. Oktober Aussteller und Besucher mit dem Ziel der Geschäftsanbahnung zusammen. Als europäische Leitmesse für Biotechnologie, Life Sciences und Labortechnik ist sie Branchentreff Nummer eins.
„Die stetig wachsende Bedeutung und die Innovationskraft der Branche spiegeln sich auf der Biotechnica wider", sagt Dr. Jochen Köckler, Mitglied des Vorstands der Deutschen Messe AG, Hannover. „Wo die Biotechnologie steht und wo es hingehen wird, sehen wir in Hannover. Wir freuen uns sehr auf die Präsentation der Schweiz, die im Bereich Biotechnologie weltweit zur Spitzengruppe gehört.
Als erstes Partnerland der Biotechnica wird sie der Messe sowie der internationalen Biotech-Branche wichtige Impulse geben." Im Zentrum der Veranstaltung stehen Technologien und Innovationen aus Forschung und Entwicklung ebenso wie biotechnologische Produkte und Anwendungen aus den Bereichen Medizin, Landwirtschaft, Ernährung, industrielle Biotechnologie und Umwelt. Hinzu kommt ein großes Spektrum an Dienstleistungen für die Biotech- und Pharma-Industrie.
Die Messe gilt zudem als entscheidende Plattform für die Zusammenführung von Innovatoren und Kapitalgebern. Die Messe beginnt am Montag, 7. Oktober, mit einer Reihe spannender Vorträge aus den unterschiedlichen Themenbereichen. Es sprechen Olaf Lies, Niedersächsischer Minister für Wirtschaft, Arbeit und Verkehr, Dr. Frank Mathias, Chairman bei vfa bio und CEO der MediGene AG, sowie Harald Bormann, Geschäftsführer der Schweizer Roche Diagnostics AG.
Fokus auf Bioökonomie
Ein Schwerpunktthema der diesjährigen Veranstaltung ist Bioökonomie. „Die Bioökonomie ist zunehmend ein Wirtschaftsfaktor mit einem enormen Wachstumspotenzial", sagt Köckler. „Weltweite Ernährungssicherheit bei gesunden Lebensmitteln, nachhaltige Agrarproduktion, die industrielle Nutzung nachwachsender Rohstoffe und die Nutzung regenerativer Energien sind auf internationaler Ebene zentrale Herausforderungen, um nach und nach die erdölbasierte Wirtschaft durch eine biobasierte Wirtschaft zu ersetzen."
So hat etwa die Bundesregierung mit der Nationalen Forschungsstrategie BioÖkonomie 2030 das klare Ziel gesetzt, Deutschland zu einem führenden Forschungs- und Innovationstandort in der Bioökonomie zu entwickeln, um den weltweiten Strukturwandel maßgeblich mit voranzutreiben. Auf der Biotechnica wird deutlich, in wie vielen Bereichen bereits auf erneuerbare biologische Ressourcen gesetzt wird, um nachhaltig und effizient zu produzieren und entsprechende Dienstleistungen anzubieten.
Marktplätze bilden Trends der Branche ab
Die 20.Biotechnica präsentiert sich außerdem mit einer neuen Darstellungsform: Verschiedene Marktplätze bilden jeweils ein aktuelles Thema der Branche ab und geben der Messe damit eine zusätzliche Struktur. Darauf zu finden sind jeweils Einzelaussteller, Gemeinschaftsstände mit einem angeschlossenen Forum für Vorträge von Wissenschaftlern und Unternehmensvertretern sowie Networking-Angebote und Posterpräsentationen.
Die Themen der Marktplätze sind Personalized Medicine Technologies, Innovation in Food, Industrial Biotechnology und BioServices. Auf dem Marktplatz Personalisierte Medizin- Technologien dreht sich alles um molekulare Diagnostik und die damit zusammenhängenden individualisierten Therapieansätze. Im Forum spielen Themen wie Next Generation Sequencing, Cellbased Asseys, Biomarker, Companion Diagnostics oder Molecular Imaging eine Rolle. Unter anderem konnten hier die deutschen Spitzencluster auf diesem Gebiet, Bio Deutschland, der Verband der Diagnostica-Industrie (VDGH), der Verband der forschenden Pharmaunternehmen (Vfa) und die Verbandsabteilung vfa bio, gewonnen werden. Der Marktplatz für Industrielle Biotechnologie stellt die Themen Biokatalyse, Bioprozesstechnik und Biorenewables in den Mittelpunkt.
Hierbei wird ein Bogen von der Entwicklung neuer Produkteigenschaften über innovative biokatalytische Prozesse und deren Skalierung auf industrielle Maßstäbe bis hin zum Management integrierter Stoffströme in komplexen Bioraffinerien gespannt. Neu ist auch das Format „Bioeconomy‘s Next Business Model", bei dem sich an zwei Tagen je sechs junge kleine und mittelständische europäische Unternehmen aus dem Bereich der industriellen Biotechnologie in kurzen Elevator-Pitches mit ihren Geschäftskonzepten präsentieren. Eine Jury kürt jeweils die Tagesgewinner.
Attraktives Rahmenprogramm ergänzt die Ausstellung
Zusätzlich zur Ausstellung bietet die Veranstaltung ein umfassendes Konferenz- und Rahmenprogramm. Ein Höhepunkt ist die Verleihung des 10. European Biotechnica Award während der offiziellen Eröffnungsfeier der Messe. Das Leitmotto für den Wettbewerb lautet in diesem Jahr „Integration of Biotechnology into the industry". Ausgezeichnet werden europäische Firmen, die biotechnologische Prozesse nutzen und Produkte erfolgreich in den Markt eingeführt haben.
Kontakt
Katharina Siebert
Deutsche Messe AG, Hannover
Tel.: +49 511 89 31028
katharina.siebert@messe.de
Meist gelesen

Zukunft Chemie: Der Strukturwandel beginnt
Die deutsche Industrie steht vor großen Herausforderungen und die Szenarien reichen von schleichendem Wohlstandsverlust bis hin zu neuem wirtschaftlichem Aufschwung.

Die zentrale Rolle katalytischer Gasreinigung entlang der Wasserstoffwertschöpfungskette
Die Wasserstoffwirtschaft befindet sich im Wandel: Der Übergang von grauem zu grünem und blauem Wasserstoff stellt neue Anforderungen an die Gasreinigung.

KI im Engineering
Rösberg Engineering hat ein KI-Projekt aufgesetzt; bei dem eine Datenbasis, Infrastruktur und verschiedene Lösungen für KI-gestütztes Engineering entstehen

Standardisierung mit der Verwaltungsschale
Durch Standardisierung via Verwaltungsschale und innovative OT-Security-Konzepte gelingt der Spagat zwischen Effizienz und Security auch bei der Digitalisierung der funktionalen Sicherheit.

Kapital für den Wandel
Private-Equity-Investoren wirken als Katalysatoren für die Konsolidierung der Chemieindustrie.








